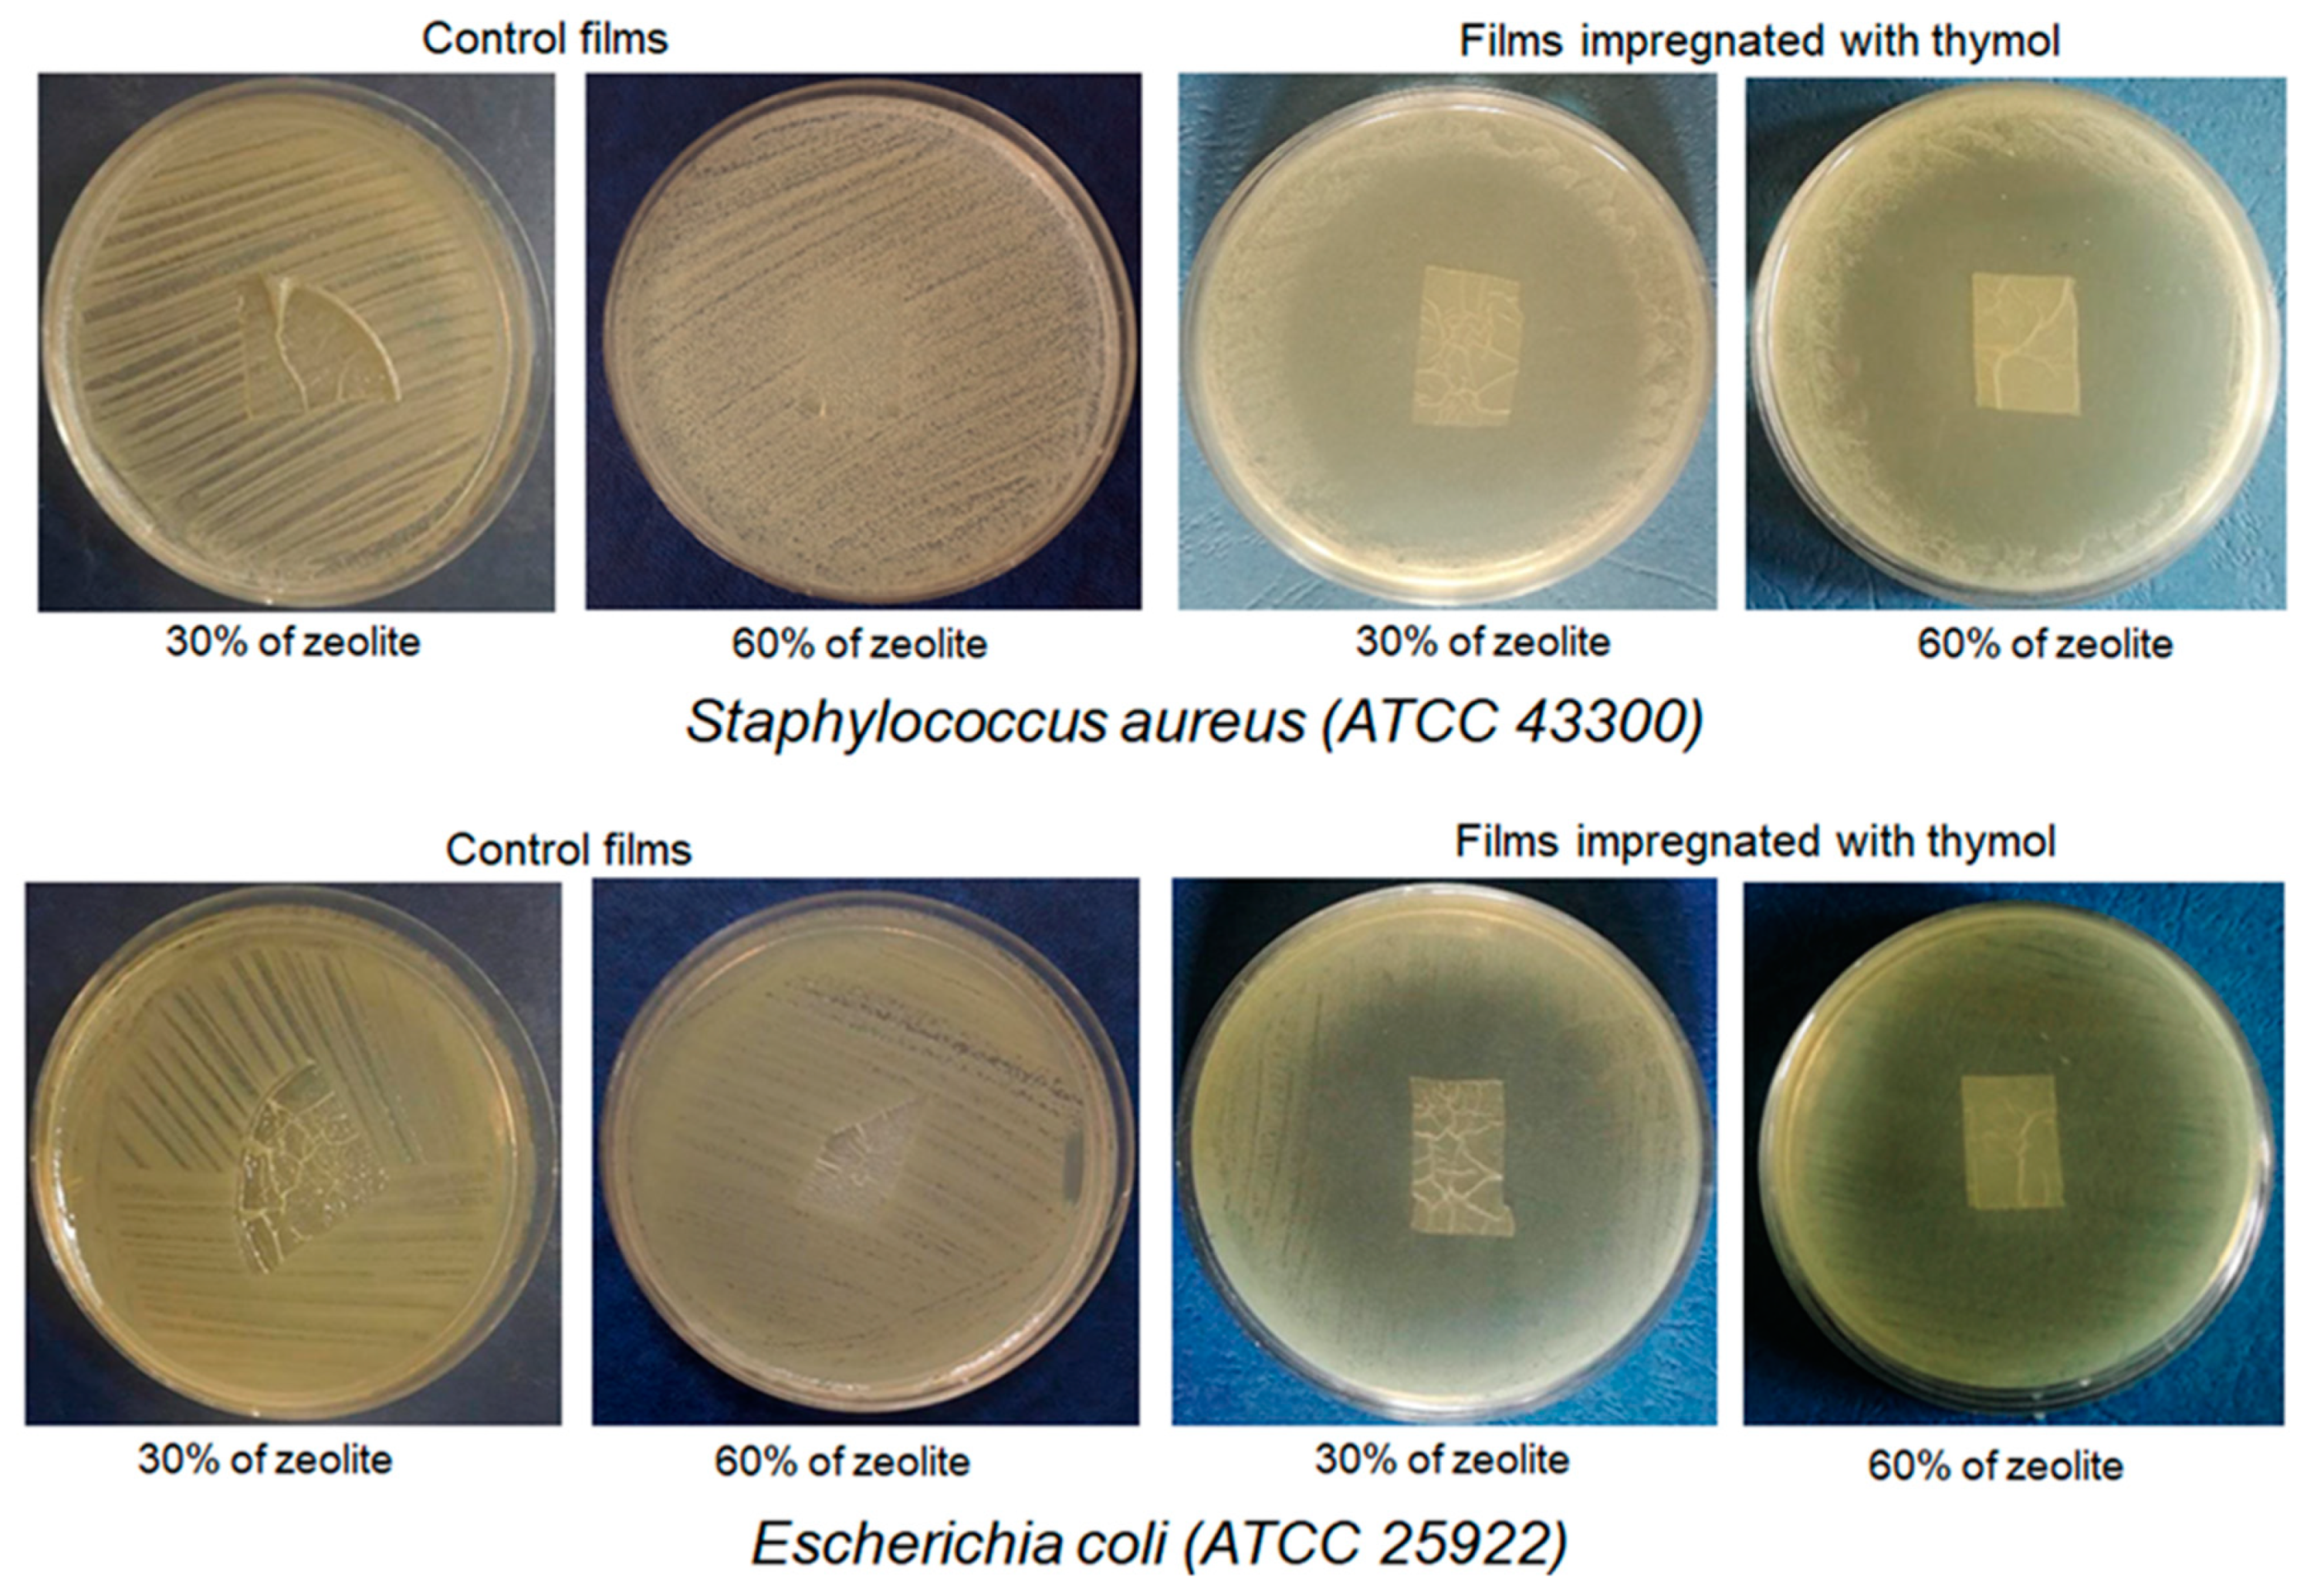
Molecules 25 04717 g007 Molecules 25 04717 g007

Application of Supercritical Solvent Impregnation for Production of Zeolite Modified Starch-Chitosan Polymers with Antibacterial Properties
Abstract
1. Introduction
2. Results and Discussion
2.1. Impregnation in Supercritical Carbon Dioxide
2.1.1. Impregnation of SC Films
2.1.2. Impregnation of SCZ Films
2.2. Fourier Transform Infrared Analysis
2.3. Mechanical Properties of the Films
2.4. Scanning Electron Microscopy (SEM) of the Films
2.5. Thermogravimetric and Derivative Thermogravimetric Analysis
2.6. Water Vapor Permeability of the Films
2.7. Release Kinetics
2.8. Antibacterial Activity
3. Materials and Methods
3.1. Materials
3.2. Preparation of Zeolite Sample
3.3. SC and SCZ Films Preparation
3.4. Supercritical Impregnation
3.5. Re-Extraction of the Impregnated Samples
3.6. Characterization of the Samples
3.6.1. FTIR Analysis
3.6.2. SEM Analysis
3.6.3. TGA-DTG Analysis
3.6.4. Mechanical Analysis
3.6.5. Water Vapor Permeability
3.7. Release Kinetics
3.8. Antibacterial Activity
4. Conclusions
Author Contributions
Funding
Acknowledgments
Conflicts of Interest
References
- Ramos, M.; Jiménez, A.; Peltzer, M.; Garrigós, M.C. Characterization and antimicrobial activity studies of polypropylene films with carvacrol and thymol for active packaging. J. Food Eng. 2012, 109, 513–519. [Google Scholar] [CrossRef]
- Mohebi, E.; Marquez, L. Intelligent packaging in meat industry: An overview of existing solutions. J. Food Sci. Technol. 2014, 52, 3947–3964. [Google Scholar] [CrossRef] [PubMed]
- Ramos, M.; Beltran, A.; Valdes, A.; Peltzer, M.; Jiménez, A.; E Zaikov, M.C.G.A.G. Carvacrol and Thymol for Fresh Food Packaging. J. Bioequivalence Bioavailab. 2013, 5, 154–160. [Google Scholar] [CrossRef]
- Misic, D.; Tadić, V.; Korzeniowska, M.; Nisavic, J.; Aksentijevic, K.; Kuzmanovic, J.; Zizovic, I. Supercritical Fluid Extraction of Celery and Parsley Fruit-Chemical Composition and Antibacterial Activity. Molecules 2020, 25, 3163. [Google Scholar] [CrossRef] [PubMed]
- Soković, M.; Van Griensven, L.J.L.D. Antimicrobial activity of essential oils and their components against the three major pathogens of the cultivated button mushroom, Agaricus bisporus. Eur. J. Plant Pathol. 2006, 116, 211–224. [Google Scholar] [CrossRef]
- Marjanović, S.Đ.; Danica, B.; Milovanović, M.; Marinković, D.; Zdravković, N.; Magaš, V.; Trailović, M.S. Antihelminic Activity of Carvacrol, Thymol, Cinnamaldehyde and P-Cymen Against the Free-Living Nematode Caenorhabditis elegans and Rat Pinworm Syphacia muris. Acta Vet. 2018, 68, 445–456. [Google Scholar] [CrossRef]
- Ramos, M.; Beltrán, A.; Peltzer, M.; Valente, A.J.M.; Garrigós, M.C. Release and antioxidant activity of carvacrol and thymol from polypropylene active packaging films. LWT 2014, 58, 470–477. [Google Scholar] [CrossRef]
- Krepker, M.; Shemesh, R.; Poleg, Y.D.; Kashi, Y.; Vaxman, A.; Segal, E. Active food packaging films with synergistic antimicrobial activity. Food Control 2017, 76, 117–126. [Google Scholar] [CrossRef]
- Mehdizadeh, T.; Tajik, H.; Rohani, S.M.R.; Oromiehie, A.R. Antibacterial, antioxidant and optical properties of edible starch-chitosan composite film containing Thymus kotschyanus essential oil. Veter- Res. Forum Int. Q. J. 2012, 3, 167–173. [Google Scholar]
- Quesada, J.; Sendra, E.; Navarro, C.; Sayas-Barberá, E. Antimicrobial Active Packaging including Chitosan Films with Thymus vulgaris L. Essential Oil for Ready-to-Eat Meat. Foods 2016, 5, 57. [Google Scholar] [CrossRef]
- Lozano-Navarro, J.I.; Díaz-Zavala, N.P.; Velasco-Santos, C.; Martínez-Hernández, A.L.; Tijerina-Ramos, B.I.; García-Hernández, M.; Rivera-Armenta, J.L.; Páramo-García, U.; La Torre, A.I.R.-D. Antimicrobial, Optical and Mechanical Properties of Chitosan–Starch Films with Natural Extracts. Int. J. Mol. Sci. 2017, 18, 997. [Google Scholar] [CrossRef] [PubMed]
- Godelitsas, A.; Armbruster, T.; Godelitsas, A.; Armbruster, T. HEU-type zeolites modified by transition elements and lead. Microporous Mesoporous Mater. 2003, 61, 3–24. [Google Scholar] [CrossRef]
- Auerbach, S.M.; Carrado, K.A.; Dutta, P.K. Handbook of Zeolite Science and Technology; CRC Press: Boca Raton, FL, USA, 2003; p. 39. [Google Scholar]
- Rodríguez-Fuentes, G.; Barrios, M.; Iraizoz, A.; Perdomo, I.; Cedré, B. Enterex: Anti-diarrheic drug based on purified natural clinoptilolite. Zeolites 1997, 19, 441–448. [Google Scholar] [CrossRef]
- Farías, T.; De Ménorval, L.; Zajac, J.; Rivera, A. Solubilization of drugs by cationic surfactants micelles: Conductivity and 1H NMR experiments. Colloids Surfaces A Physicochem. Eng. Asp. 2009, 345, 51–57. [Google Scholar] [CrossRef]
- Hayakawa, K.; Mouri, Y.; Maeda, T.; Satake, I.; Sato, M. Surfactant-modified zeolites as a drug carrier and the release of chloroquin. Colloid Polym. Sci. 2000, 278, 553–558. [Google Scholar] [CrossRef]
- Li, Z.; Bowman, R.S. Sorption of Perchloroethylene by Surfactant-Modified Zeolite as Controlled by Surfactant Loading. Environ. Sci. Technol. 1998, 32, 2278–2282. [Google Scholar] [CrossRef]
- Rodríguez-Fuentes, G.; Denis, A.R.; Álvarez, M.A.B.; Colarte, A.I. Antacid drug based on purified natural clinoptilolite. Microporous Mesoporous Mater. 2006, 94, 200–207. [Google Scholar] [CrossRef]
- Kaya, D.A.; Vuluga, Z.; Nicolae, C.A.; Radovici, C.; Albu, M.G. The properties of two natural zeolites modified with oregano essential oil. Rom. J. Mater. 2013, 43, 48–54. [Google Scholar]
- Milovanović, S.L.; Janković-Častvan, I.; Ivanovic, J.; Zizovic, I. Effect of starch xero- and aerogels preparation on the supercritical CO2 impregnation of thymol. Starch Stärke 2014, 67, 174–182. [Google Scholar] [CrossRef]
- Milovanovic, S.; Markovic, D.; Aksentijevic, K.; Stojanovic, D.B.; Ivanovic, J.; Zizovic, I. Application of cellulose acetate for controlled release of thymol. Carbohydr. Polym. 2016, 147, 344–353. [Google Scholar] [CrossRef]
- Dias, A.M.A.; Braga, M.E.; Seabra, I.J.; Ferreira, P.; Gil, M.H.; De Sousa, H.C. Development of natural-based wound dressings impregnated with bioactive compounds and using supercritical carbon dioxide. Int. J. Pharm. 2011, 408, 9–19. [Google Scholar] [CrossRef] [PubMed]
- Zizovic, I.; Ivanovic, J.; Milovanovic, S.; Stamenic, M. Supercritical CO2 Extration and its Applications. In Impregnations Using Supercritical Carbon Dioxide; Rój, E., Ed.; OIC Poland: Lublin, Poland, 2014; pp. 23–34. [Google Scholar]
- Kikic, I.; Vecchione, F. Supercritical impregnation of polymers. Curr. Opin. Solid State Mater. Sci. 2003, 7, 399–405. [Google Scholar] [CrossRef]
- Wu, Y.; Qin, Y.; Yuan, M.; Li, L.; Chen, H.; Cao, J.; Yang, J. Characterization of an antimicrobial poly(lactic acid) film prepared with poly(ε -caprolactone) and thymol for active packaging. Polym. Adv. Technol. 2014, 25, 948–954. [Google Scholar] [CrossRef]
- Zizovic, I. Supercritical Fluid Applications in the Design of Novel Antimicrobial Materials. Molecules 2020, 25, 2491. [Google Scholar] [CrossRef] [PubMed]
- Milovanović, S.L.; Adamović, T.N.; Aksentijevic, K.; Misic, D.; Ivanovic, J.; Zizovic, I. Cellulose Acetate Based Material with Antibacterial Properties Created by Supercritical Solvent Impregnation. Int. J. Polym. Sci. 2017, 2017, 1–9. [Google Scholar] [CrossRef]
- Goñi, M.L.; Gañán, N.A.; Strumia, M.C.; Martini, R.E. Eugenol-loaded LLDPE films with antioxidant activity by supercritical carbon dioxide impregnation. J. Supercrit. Fluids 2016, 111, 28–35. [Google Scholar] [CrossRef]
- Medeiros, G.R.; Ferreira, S.R.; Carciofi, B.A. High pressure carbon dioxide for impregnation of clove essential oil in LLDPE films. Innov. Food Sci. Emerg. Technol. 2017, 41, 206–215. [Google Scholar] [CrossRef]
- Torres, A.; Romero, J.; Macan, A.; Guarda, A.; Galotto, M.J. Near critical and supercritical impregnation and kinetic release of thymol in LLDPE films used for food packaging. J. Supercrit. Fluids 2014, 85, 41–48. [Google Scholar] [CrossRef]
- Bastante, C.C.; Cardoso, L.C.; Serrano, C.M.; De La Ossa, E.M. Supercritical impregnation of food packaging films to provide antioxidant properties. J. Supercrit. Fluids 2017, 128, 200–207. [Google Scholar] [CrossRef]
- Torres, A.; Ilabaca, E.; Rojas, A.; Rodríguez, F.; Galotto, M.J.; Guarda, A.; Villegas, C.; Romero, J. Effect of processing conditions on the physical, chemical and transport properties of polylactic acid films containing thymol incorporated by supercritical impregnation. Eur. Polym. J. 2017, 89, 195–210. [Google Scholar] [CrossRef]
- Milovanovic, S.; Hollermann, G.; Errenst, C.; Pajnik, J.; Frerich, S.; Kroll, S.; Rezwan, K.; Ivanovic, J. Supercritical CO2 impregnation of PLA/PCL films with natural substances for bacterial growth control in food packaging. Food Res. Int. 2018, 107, 486–495. [Google Scholar] [CrossRef] [PubMed]
- Zizovic, I.; Senerovic, L.; Morić, I.; Adamović, T.; Jovanović, M.; Krušić, M.T.K.; Misic, D.; Stojanovic, D.B.; Milovanovic, S. Utilization of supercritical carbon dioxide in fabrication of cellulose acetate films with anti-biofilm effects against Pseudomonas aeruginosa and Staphylococcus aureus. J. Supercrit. Fluids 2018, 140, 11–20. [Google Scholar] [CrossRef]
- Milovanović, S.L.; Stamenić, M.; Markovic, D.; Radetić, M.; Zizovic, I. Solubility of thymol in supercritical carbon dioxide and its impregnation on cotton gauze. J. Supercrit. Fluids 2013, 84, 173–181. [Google Scholar] [CrossRef]
- Ivanovic, J.; Knauer, S.; Fanovich, A.; Milovanović, S.L.; Stamenic, M.; Jaeger, P.; Zizovic, I.; Eggers, R. Supercritical CO2 sorption kinetics and thymol impregnation of PCL and PCL-HA. J. Supercrit. Fluids 2016, 107, 486–498. [Google Scholar] [CrossRef]
- Ren, L.; Yan, X.; Zhou, J.; Tong, J.; Su, X. Influence of chitosan concentration on mechanical and barrier properties of corn starch/chitosan films. Int. J. Biol. Macromol. 2017, 105, 1636–1643. [Google Scholar] [CrossRef]
- Xu, Y.; Kim, K.; Hanna, M.; Nag, D. Chitosan–starch composite film: Preparation and characterization. Ind. Crop. Prod. 2005, 21, 185–192. [Google Scholar] [CrossRef]
- Ashori, A.; Bahrami, R. Modification of Physico-Mechanical Properties of Chitosan-Tapioca Starch Blend Films Using Nano Graphene. Polym. Technol. Eng. 2014, 53, 312–318. [Google Scholar] [CrossRef]
- Silva-Pereira, M.C.; Teixeira, J.A.; Pereira-Júnior, V.A.; Stefani, R. Chitosan/corn starch blend films with extract from Brassica oleraceae (red cabbage) as a visual indicator of fish deterioration. LWT 2015, 61, 258–262. [Google Scholar] [CrossRef]
- Tuhin, M.O.; Rahman, N.; Haque, E.; Khan, R.A.; Dafader, N.C.; Islam, R.; Nurnabi, M.; Tonny, W. Modification of mechanical and thermal property of chitosan–starch blend films. Radiat. Phys. Chem. 2012, 81, 1659–1668. [Google Scholar] [CrossRef]
- Yumin, D.; Zuyong, X.; Rong, L. Blendfilms of chitosan/starch. J. Nat. Sci. 1997, 2, 220–224. [Google Scholar]
- Pechar, F.; Rykl, D. Infrared spectra of natural zeolites of the stilbite group. Chem. Zves. 1981, 35, 189–202. [Google Scholar]
- Favvas, E.P.; Tsanaktsidis, C.G.; Sapalidis, A.A.; Tzilantonis, G.T.; Papageorgiou, S.K.; Mitropoulos, A.C. Clinoptilolite, a natural zeolite material: Structural characterization and performance evaluation on its dehydration properties of hydrocarbon-based fuels. Microporous Mesoporous Mater. 2016, 225, 385–391. [Google Scholar] [CrossRef]
- Kittur, A.; Kulkarni, S.; Aralaguppi, M.; Kariduraganavar, M. Preparation and characterization of novel pervaporation membranes for the separation of water–isopropanol mixtures using chitosan and NaY zeolite. J. Membr. Sci. 2005, 247, 75–86. [Google Scholar] [CrossRef]
- Shahidi, S.; Aslan, N.; Ghoranneviss, M.; Korachi, M. Effect of thymol on the antibacterial efficiency of plasma-treated cotton fabric. Cellulose 2014, 21, 1933–1943. [Google Scholar] [CrossRef]
- Marković, D.; Milovanović, S.L.; Radetić, M.; Jokić, B.; Zizovic, I. Impregnation of corona modified polypropylene non-woven material with thymol in supercritical carbon dioxide for antimicrobial application. J. Supercrit. Fluids 2015, 101, 215–221. [Google Scholar] [CrossRef]
- Sokrates, G. Infrared and Raman Characteristic Group Frequencies—Tables and Charts; John Wiley and Sons: New York, NY, USA, 2001. [Google Scholar]
- Mohammed, M.; Al-Bayati, F.A. Isolation and identification of antibacterial compounds from Thymus kotschyanus aerial parts and Dianthus caryophyllus flower buds. Phytomedicine 2009, 16, 632–637. [Google Scholar] [CrossRef]
- Santacruz, S.; Rivadeneira, C.; Castro, M. Edible films based on starch and chitosan. Effect of starch source and concentration, plasticizer, surfactant’s hydrophobic tail and mechanical treatment. Food Hydrocoll. 2015, 49, 89–94. [Google Scholar] [CrossRef]
- Bonilla, J.; Talón, E.; Atarés, L.; Vargas, M.; Chiralt, A. Effect of the incorporation of antioxidants on physicochemical and antioxidant properties of wheat starch–chitosan films. J. Food Eng. 2013, 118, 271–278. [Google Scholar] [CrossRef]
- Wang, J.; Zheng, X.; Wu, H.; Zheng, B.; Jiang, Z.; Hao, X.; Wang, B. Effect of zeolites on chitosan/zeolite hybrid membranes for direct methanol fuel cell. J. Power Sources 2008, 178, 9–19. [Google Scholar] [CrossRef]
- Chivrac, F.; Gueguen, O.; Pollet, E.; Ahzi, S.; Makradi, A.; Avérous, L. Micromechanical modeling and characterization of the effective properties in starch-based nano-biocomposites. Acta Biomater. 2008, 4, 1707–1714. [Google Scholar] [CrossRef]
- Peng, Y.; Li, Y. Combined effects of two kinds of essential oils on physical, mechanical and structural properties of chitosan films. Food Hydrocoll. 2014, 36, 287–293. [Google Scholar] [CrossRef]
- Singh, V. Synthesis and characterization of chitosan-starch crosslinked beds. In Advanced Polymeric Materials: From Macro- to Nano-Length Scales; Thomas, S., Kalarikkal, N., Jaroszewski, M., Jose, J.P., Eds.; Taylor & Francis Group: New York, NY, USA, 2016; pp. 205–218. [Google Scholar]
- Radovic, M.; Adamovic, T.; Pavlovic, J.; Rusmirovic, J.; Tadic, V.; Branković, Z.; Ivanovic, J. Supercritical CO2 impregnation of Gelatin-Chitosan films with clove essential oil and characterization thereof. Chem. Ind. Chem. Eng. Q. 2019, 25, 119–130. [Google Scholar] [CrossRef]
- Mathew, S.; Abraham, T.E. Characterisation of ferulic acid incorporated starch–chitosan blend films. Food Hydrocoll. 2008, 22, 826–835. [Google Scholar] [CrossRef]
- Akter, N.; Khan, R.A.; Tuhin, M.O.; Haque, M.E.; Nurnabi, M.; Parvin, F.; Islam, R. Thermomechanical, barrier, and morphological properties of chitosan-reinforced starch-based biodegradable composite films. J. Thermoplast. Compos. Mater. 2012, 27, 933–948. [Google Scholar] [CrossRef]
- Li, X.; Yang, X.; Deng, H.; Guo, Y.; Xue, J. Gelatin films incorporated with thymol nanoemulsions: Physical properties and antimicrobial activities. Int. J. Biol. Macromol. 2020, 150, 161–168. [Google Scholar] [CrossRef] [PubMed]
- Medina, E.; Caro, N.; Abugoch, L.; Gamboa, A.; Díaz-Dosque, M.; Tapia, C. Chitosan thymol nanoparticles improve the antimicrobial effect and the water vapour barrier of chitosan-quinoa protein films. J. Food Eng. 2019, 240, 191–198. [Google Scholar] [CrossRef]
- Tripathi, S.; Mehrotra, G.K.; Dutta, P.K. Chitosan based antimicrobial films for food packaging applications. e-Polymers 2008, 8, 1082–1088. [Google Scholar] [CrossRef]
- Fernandez-Pan, I.; Mate, J.I.; Gardrat, C.; Coma, V. Effect of chitosan molecular weight on the antimicrobial activity and release rate of carvacrol-enriched films. Food Hydrocoll. 2015, 51, 60–68. [Google Scholar] [CrossRef]
- Kurek, M.; Descours, E.; Galić, K.; Voilley, A.; Debeaufort, F. How composition and process parameters affect volatile active compounds in biopolymer films. Carbohydr. Polym. 2012, 88, 646–656. [Google Scholar] [CrossRef]
- Milovanovic, S.; Markovic, D.; Mrakovic, A.; Kuska, R.; Zizovic, I.; Frerich, S.; Ivanovic, J. Supercritical CO2-assisted production of PLA and PLGA foams for controlled thymol release. Mater. Sci. Eng. C 2019, 99, 394–404. [Google Scholar] [CrossRef]
- Talón, E.; Trifkovic, K.T.; Vargas, M.; Chiralt, A.; González-Martínez, C. Release of polyphenols from starch-chitosan based films containing thyme extract. Carbohydr. Polym. 2017, 175, 122–130. [Google Scholar] [CrossRef] [PubMed]
- Korsmeyer, R.W.; Peppas, N.A. Effect of the morphology of hydrophilic polymeric matrices on the diffusion and release of water soluble drugs. J. Membr. Sci. 1981, 9, 211–227. [Google Scholar] [CrossRef]
- Papadopoulou, V.; Kosmidis, K.; Vlachou, M.; Macheras, P. On the use of the Weibull function for the discernment of drug release mechanisms. Int. J. Pharm. 2006, 309, 44–50. [Google Scholar] [CrossRef] [PubMed]
- Wayne, P.A. Performance Standards for Antimicrobial Susceptibility Testing, 27th ed.; CLSI supplement M100S; Clinical and Laboratory Standards Institute: Wayne, PA, USA, 2017. [Google Scholar]
- Stefanovič, S.C.; Logar, N.Z.; Margeta, K.; Tušar, N.N.; Arcon, I.; Maver, K.; Kovac, J.; Kaucic, V. Structural investigation of Zn2+ sorption on clinoptilolite tuff from the Vranjska Banja deposit in Serbia. Microporous Mesoporous Mater. 2007, 105, 251–259. [Google Scholar] [CrossRef]
- Stojakovic, D.; Milenkovic, J.; Daneu, N.; Rajic, N. A study of the removal of copper ions from aqueous solution using clinoptilolite from Serbia. Clays Clay Miner. 2011, 59, 277–285. [Google Scholar] [CrossRef]
- Hosseini, M.; Razavi, S.H.; Mousavi, S.M. Antimicrobial, physical and mechanical properties of chitosan-based films incorporated with thyme, clove and cinnamon essential oils. J. Food Process. Preserv. 2009, 33, 727–743. [Google Scholar] [CrossRef]
- Gennadios, A.; Hanna, M.; Kurth, L. Application of Edible Coatings on Meats, Poultry and Seafoods: A Review. LWT 1997, 30, 337–350. [Google Scholar] [CrossRef]
- Martí, M.; Frígols, B.; Serrano-Aroca, A. Antimicrobial Characterization of Advanced Materials for Bioengineering Applications. J. Vis. Exp. 2018, 138, e57710. [Google Scholar] [CrossRef]
Sample Availability: Samples of the compounds are not available from the authors. Publisher’s Note: MDPI stays neutral with regard to jurisdictional claims in published maps and institutional affiliations. |

| Sample | σT (MPa) | E (MPa) | ε (%) |
|---|---|---|---|
| SC | 10.2 ± 1.8 | 203 ± 19 | 20.1 ± 6.9 |
| SCT | 10.2 ± 2.3 | 449 ± 52 | 10.0 ± 2.3 |
| SCZ (15%) | 9.1 ± 2.1 | 419 ± 93 | 2.5 ± 0.3 |
| SCZT (15%) | 9.7 ± 0.9 | 466 ± 65 | 3.1 ± 0.2 |
| SCZ (30%) | 6.3 ± 0.7 | 321 ± 55 | 3.7 ± 0.7 |
| SCZT (30%) | 7.8 ± 0.6 | 447 ± 63 | 3.1 ± 0.4 |
| SCZ (60%) | 6.6 ± 1.1 | 380 ± 68 | 2.8 ± 0.8 |
| SCZT (60%) | 6.1 ± 1.3 | 623 ± 130 | 1.4 ± 0.2 |
| Sample | WVP × 1011 (gm−1s−1Pa−1) |
|---|---|
| SC | 1.78 ± 0.12 |
| SCT | 1.70 ± 0.14 |
| SCZ (15%) | 2.21 ± 0.21 |
| SCZT (15%) | 1.97 ± 0.18 |
| SCZ (30%) | 2.71 ± 0.20 |
| SCZT (30%) | 2.54 ± 0.24 |
| Film | Korsmeyer–Peppas Equation (3) | Weibull Equation (4) | ||||
|---|---|---|---|---|---|---|
| k, h−n | n | R2 | a | b | R2 | |
| SCT | 0.314 | 0.0012 | 0.630 | 0.377 | 0.0015 | 0.630 |
| SCZT (15%) | 0.305 | 0.132 | 0.936 | 0.362 | 0.170 | 0.938 |
| SCZT (30%) | 0.330 | 0.029 | 0.975 | 0.402 | 0.030 | 0.968 |
© 2020 by the authors. Licensee MDPI, Basel, Switzerland. This article is an open access article distributed under the terms and conditions of the Creative Commons Attribution (CC BY) license (http://creativecommons.org/licenses/by/4.0/).
Share and Cite
Pajnik, J.; Lukić, I.; Dikić, J.; Asanin, J.; Gordic, M.; Misic, D.; Zizović, I.; Korzeniowska, M. Application of Supercritical Solvent Impregnation for Production of Zeolite Modified Starch-Chitosan Polymers with Antibacterial Properties. Molecules 2020, 25, 4717. https://doi.org/10.3390/molecules25204717
Pajnik J, Lukić I, Dikić J, Asanin J, Gordic M, Misic D, Zizović I, Korzeniowska M. Application of Supercritical Solvent Impregnation for Production of Zeolite Modified Starch-Chitosan Polymers with Antibacterial Properties. Molecules. 2020; 25(20):4717. https://doi.org/10.3390/molecules25204717
Chicago/Turabian StylePajnik, Jelena, Ivana Lukić, Jelena Dikić, Jelena Asanin, Milan Gordic, Dusan Misic, Irena Zizović, and Malgorzata Korzeniowska. 2020. "Application of Supercritical Solvent Impregnation for Production of Zeolite Modified Starch-Chitosan Polymers with Antibacterial Properties" Molecules 25, no. 20: 4717. https://doi.org/10.3390/molecules25204717
APA StylePajnik, J., Lukić, I., Dikić, J., Asanin, J., Gordic, M., Misic, D., Zizović, I., & Korzeniowska, M. (2020). Application of Supercritical Solvent Impregnation for Production of Zeolite Modified Starch-Chitosan Polymers with Antibacterial Properties. Molecules, 25(20), 4717. https://doi.org/10.3390/molecules25204717

